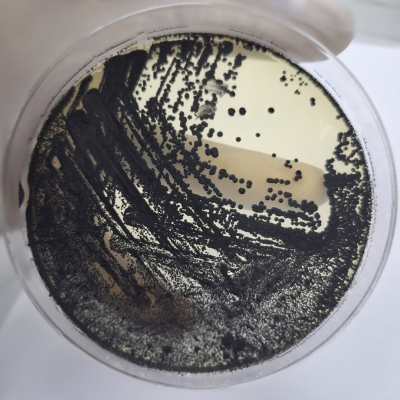
2
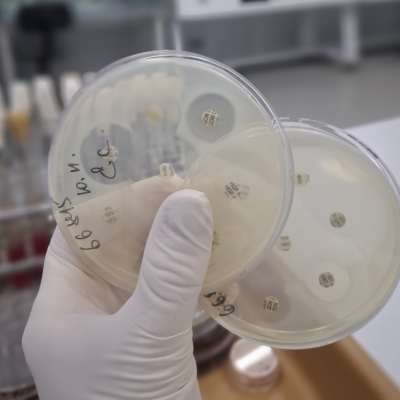
6

В отдел бактериологии, паразитологии и питательных сред Краснодарской испытательной лаборатории ФГБУ «ВНИИЗЖ» доставлена проба помёта от попугая. При проведении бактериологических исследований обнаружена условно-патогенная микрофлора: культуры Klebsiella oxytoca, Pseudomonas aeruginosa и Enterococcus faecalis. Обнаружена патогенная культура Escherichia coli (04).
Что означает данный анализ для владельца птицы, а также ветеринарного специалиста-орнитолога?
Данные бактерии могут быть частью кишечной микрофлоры у птицы, либо представлять собой инфекционный или условно-патогенный агент (способный вызвать заболевание при неблагоприятных для птицы условиях, таких как стресс, переохлаждение, недоброкачественные корма и т.д.). Наличие кишечной палочки Escherichia coli может указывать на наличие патогенных, т.е. способных вызывать инфекционное заболевание, бактерий, либо перенаселенность кишечника данной культурой. В нашем случае первый вариант, т.к. кишечная палочка оттипировалась с диагностическими колибактериозными сыворотками — препаратами, содержащими антитела к определенным группам бактерий Escherichia coli, которые используются для идентификации возбудителя инфекции путем реакции агглютинации. Klebsiella oxytoca, Pseudomonas aeruginosa и Enterococcus faecalis также могут ассоциироваться с инфекциями у птиц или возникать в результате нарушения баланса микрофлоры, особенно при стрессе, плохих условиях содержания или заболеваниях.
Обнаружение бактерий у попугая - это предварительный этап. Для оценки риска и необходимости лечения важны симптомы заболевания у птицы, а также результаты дополнительных исследований. Если у попугая есть признаки заболевания (нарушения поведения, выделения из носа и рта, диарея, снижение аппетита), то необходима консультация ветеринарного специалиста. В случае отсутствия симптомов – могут потребоваться наблюдение и профилактика. Владельцы животного отмечали, что после переезда на новое место жительства помет у птицы стал жидким, водянистой консистенции, что не является нормой. При консультации с орнитологом рекомендовано бактериологическое исследование с целью назначения индивидуального лечения для пернатого питомца.
Правильно и своевременно поставленный диагноз позволит вам грамотно провести лечение с учётом чувствительности выделенной микрофлоры к антибактериальным препаратам, в том числе при необходимости к бактериофагам, получить лечебный эффект. Врачи отдела бактериологии, паразитологии и питательных сред Краснодарской испытательной лаборатории ФГБУ «ВНИИЗЖ» имеют обширный опыт в диагностике условно-патогенной и патогенной микрофлоры у птиц при помощи классических бактериологических методов, а также импортных и отечественных тест-систем. Срок исследования на УПМ обычно составляет 5-7 рабочих дней. Выданная чувствительность к антибактериальным препаратам позволит назначить питомцу наиболее эффективный и доступный препарат (обычно чувствительность ставится на 6 или 18 антибактериальных препаратов, клиент может указать в сопроводительном документе те препараты, на которые предпочтительнее проверить чувствительность). Специалисты с удовольствием окажут консультативную помощь в вопросах лечения и профилактики данной инфекции.